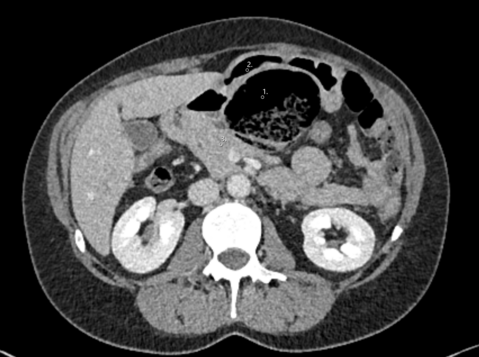

Case Description:
An 83-year-old patient presented at our emergency department with a 24-hour history of dizziness, balance impairment, chills, high fever of 39°C, as well as mild discomfort in both the left and right upper abdominal quadrants. Additionally, the patient reported vomiting on three occasions during the day of presentation. The vital signs on admission were Blood pressure 116/63 mmHg, pulse rate 85 bpm and an oxygen saturation of 96%.
The patient was known for chronic myeloid leukemia, a prior episode of urothelial carcinoma, the presence of multiple renal cysts, and the diagnosis of a saccular juxtarenal aortic aneurysm since October 2021, which has been subject to annual surveillance. The most recent assessment took place five days before the patient presented at our emergency department and showed a stable saccular aortic aneurysm measuring 4.8 cm x 2.7 cm, using ultrasound. Laboratory findings revealed a slightly elevated C-reactive protein (23 mg/l) while white blood cell counts remained within the normal range. Hemoglobin was 9.4 g/dl.
Given the patient's unexplained symptoms, an abdominal CT scan was performed:
What should be done next?
- Transfer the patient to the general ward and conduct a gastroscopy the following day.
- Proceed with emergency surgical intervention for repair of the aortic aneurysm.
- Insert a gastric tube and start antibiotic therapy.
- Continue outpatient management and schedule a follow-up appointment.
- Schedule an emergency endovascular stenting on the same day.
Case Solution
The appropriate answer is to proceed with emergency surgical intervention for the aortic aneurysm.
The CT scan together with the clinical symptoms confirmed the suspicion of a symptomatic aortic aneurysm necessitating immediate intervention. There was suspicion on the CT scan for an aorto-duodenal fistula. The surgical procedure performed, was an open replacement of the aorta due to the juxtarenal location of the aneurysm and the suspected presence of an aorto-duodenal fistula. A vascular surgeon, assisted by a visceral surgeon, performed the surgery. During the surgery, no evidence of an aorto-duodenal fistula was identified, leading to the decision to replace the juxtarenal aorta with a Dacron interposition Graft. Due to positive blood culture results in the perioperative period, the patient received a long-term course of antibiotic treatment. The patient, who made nonetheless a satisfactory recovery and was discharged two weeks following the surgery, rejected our suggestion of a re-laparotomy for more radical aneurysmal sac debridement and omentoplasty given the high suspicion of a mycotic aneurysm. A PET-CT scan performed six months after the surgery, revealed a graft infection. Despite this finding, the patient expressed unwillingness to undergo further surgical intervention. At the time of publication, the patient is still alive under suppressive antibiotic regimen.
The incidence of abdominal aortic aneurysms varies based on factors such as age, gender, family medical history, and tobacco use, resulting in differing prevalence rates. In summary, the typical patient with an aortic aneurysm is male, over 65 years of age, and a smoker. (1)The mortality rate associated with aortic aneurysm rupture remains at approximately 30-50%. (2)
Patients who experience a rupture typically report symptoms such as abrupt onset of back or abdominal pain, abdominal bloating, loss of consciousness, and profuse sweating. (3)
Diagnosis is typically made by bimanual abdominal palpation, ultrasound and CT scans.
Surgical intervention for infrarenal aortic aneurysms is indicated for diameters exceeding 5.5 cm in men and 5.0 cm in women. Surgery is also advised if the aneurysm demonstrates a growth rate exceeding 10 mm per year.
The treatment of aortic aneurysms involves two primary surgical approaches: open surgery by excluding the aneurysm with a vascular graft and endovascular aortic repair by covering the aneurysm with a stent graft. (4)
Treatment of native aortic aneurysm ruptures associated with intestinal fistulas are very rare and complex and leads to a high postoperative mortality. In case of an aorto-duodenal fistula, additional measures such as duodenal reconstruction, in-situ reconstruction of the aorta using a pericardial prosthesis or vein material, and omentoplasty are suggested. (3)
Given the substantial risk of mortality associated with aortic aneurysm rupture, it is advisable to recommend sonographic screening for smoking men over the age of 65. (5)
In this case, making the correct diagnosis was a challenge given the stable aneurysm dimensions in comparison to the previous imaging and due to the atypical clinical presentation. The suspicion of an aorto-duodenal fistula on CT scan prompted an open surgical approach. Due to the unfavorable anatomy for an EVAR, due to the very short infrarenal aortic neck, the possible strategy of a bridging procedure was not an option.
As a take home message, we might embrace that even unspecific abdominal symptoms in patients with abdominal aortic aneurysms warrant urgent imaging and a high level of suspicion of aneurysm related complications.
1. K.Craig Kent, Robert M.Zwolak, Natalia N. Egorova, Thomas S. Riles,Andres Manganaro, Alan J. Moskowitz, Annetine C. Gelijns, Giampaolo Greco. Analysis of risk factors for abdominal aortic aneurysm in a cohort of more than 3 million individuals. Journal of Vascular Surgery. 2010, S. 539-548.
2. L.L. Hoornweg, M.N. Storm-Versloot, D.T. Ubbink, M.J.W. Koelemay, D.A. Legemate, R. Balm. Meta analysis on mortality of ruptured abdominal aortic aneurysm. European Journal of vascular and endovascular Surgery. 2008.
3. Anders Wanhainen, Raquel Themudo, Hakan Ahlström, Lars Lind, Lars Johansson. Thoracic and abdominal aortic dimension in 70 year old men and women-A population based wwhole body magnetic resonance imaging (MRI) study. Journal of Wascular Surgery. 3. März 2008, S. 504-512.
4. Prof. Dr. med.Thomas Schmitz-Rixen, Prof. Dr. med Dittmar Böckler, Prof. Dr. med. Thomas J.Vogl, Prof. Dr. med. Reinhard T. Grundmann. Endovascular and Open Repair of Abdominal Aortic Aneurysm. Deutsches Ärzteblatt. November 2020, S. 813-819.
5. E.S. Debus, F. Heidemann, W. Gross-Fengels, A.Mahlmann et al. S3-Leitlinie zu Screening, Diagnostik, Therapie und Nachsorge des Bauchaortenaneurysmas. [Online] 2018. Juli 07. AWMF-Registernummer: 004-14.
6. Alan T Hitsch, Ziv J Haskal, Normal R Hertzer et al. ACC/AHA 2005 guidelines for the management of patients with peripheral arterial disease (lower extremity,renal,mesenteric, and abdominal aortic): executive summary a collaborative report from the American Association for Vascular Surgery/Society for Vascu. Journal of the American college of Cardiology. 21. Mai 2006.